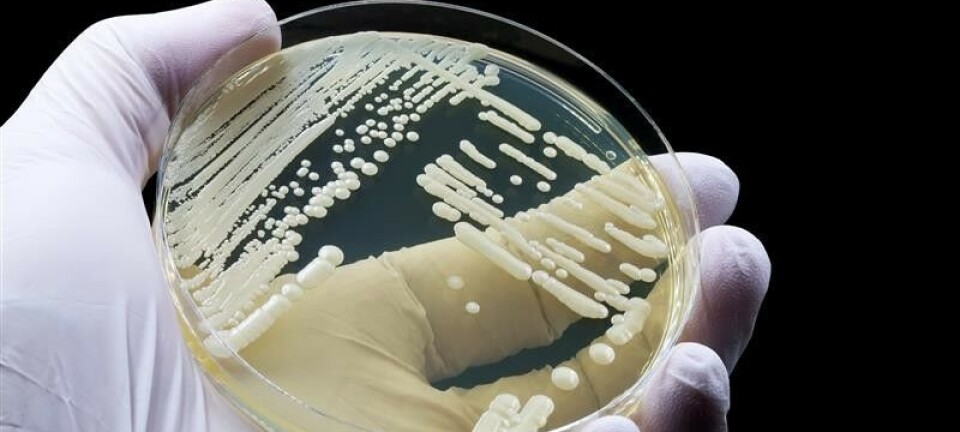

Relatert innhold
Uviss framtid for kompletterende utdanning
På OsloMet – storbyuniversitetet er ennå ingen avgjørelse tatt for framtida til den kompletterende utdanninga for bioingeniører.
Bioingeniøren omtalte saken i august i år da det ble klart at studieprogrammet ikke tok inn noen studenter i høst.
- Slik det ser ut nå, vil programmet også pauses for opptak høsten 2026, sier Ranjan Chrisanthar.
Han er avdelingsleder for bioingeniørfag og biomedisin, og studieprogramansvarlig for den kompletterende utdanninga.

Ranjan Chrisanthar har utredet den kompletterende utdanninga for bioingeniører på OsloMet. Foto: Heidi Strand Chrisanthar forteller at han er ferdig med utredning av utdanninga, og har avtalt et møte med Helsedirektoratet.
Der skal utredninga legges fram og studiets framtid drøftes.
Utdanninga har slitt med lave opptakstall og høy ressursbruk, og Chrisanthar uttalte i august at den ikke er bærekraftig, slik den er nå.
Sist opptaksår, høsten 2024, var det bare fem av 23 søkere som var kvalifiserte.
Ina Møller på NTNU hedres
Universitetslektoren på bioingeniørutdanninga i Trondheim premieres for å ha tydelig og gjennomgående fokus på studentenes læring i undervisningsvirksomheten sin på NTNU. Det skriver Universitetsavisa.
Møller får status som merittert underviser, noe som innebærer både høyere lønn og en pengepott til bioingeniørutdanningen der hun er ansatt.

Ina Møller Foto: NTNU Til Bioingeniøren sier hun:
- Jeg er utrolig glad for utnevnelsen. Jeg har i flere år jobbet med å utvikle studentaktiv undervisning som knytter utdanning og profesjonen tettere sammen.
Pengene kommer hun til å bruke på videreføring av disse prosjektene.
Prorektor for utdanning ved NTNU, Geir Egil Dahle Øien, uttaler til Universitetsavisa at de meritterte underviserne er viktige drivkrefter bak framragende utdanning. Gjennom innovativ undervisning og stort engasjement setter de en høy standard for kvaliteten på utdanning som inspirerer kolleger og studenter til å strekke seg lenger.
Hvert år får noen utvalgte vitenskapelige ansatte ved NTNU status som merittert underviser. I år var de 18, og hele lista kan leses her.
Ny avdelingsleder på UNN
Lena Oprand Heggelund er ansatt som ny avdelingsleder for Mikrobiologi og smittevern på Universitetssykehuset Nord-Norge (UNN).

Lena Oprand Heggelund utenfor avdeling for Mikrobiologi og smittevern på Universitetssykehuset Nord-Norge. Foto: privat Heggelund kommer fra stillingen som seksjonsleder for Samhandling og helsetjenesteutvikling, og har hatt flere spennende jobber både i det private og det offentlige.
- Min bakgrunn som bioingeniør og kvalitetsleder har vært et viktig grunnlag både i jobben som rådgiver/prosjektleder i Kvalitetsavdelingen i UNN og som leder i det private næringslivet, skriver Heggelund i en e-post.
I 1991 skrev hun bacheloroppgaven sin i bioingeniørfag om antibiotikaresistens nettopp på mikrobiologisk avdeling i Tromsø.
Noen tiår og en faglig rundreise senere, er hun utrolig stolt over å tiltre som avdelingsleder på samme avdeling.
I et innlegg på LinkedIn skriver hun at hun har hatt en flott oppstart i et varmt og inkluderende arbeidsmiljø, og at hun gleder seg til veien videre sammen med dyktige medarbeidere og nye kolleger.
Tre av fire yngre gravide vil ha NIPT for alle
76 prosent av gravide under 35 år vil at NIPT skal tilbys alle gravide gjennom det offentlige helsevesenet. Av disse svarte 86 prosent at det bør være gratis.
Per i dag er det gravide over 35 år som får tilbud om NIPT via det offentlige helsevesenet. Yngre gravide, uten medisinsk indikasjon, kan kjøpe testen i offentlig regi.
Det er en ny studie, publisert i Tidsskrift for Den norske legeforening, som har undersøkt holdningene til NIPT. Studien omfatter 1260 gravide under 35 år.
Non-invasiv prenatal test (NIPT) er en blodprøve fra mor som kan angi risikoen for trisomi 13, 18 og 21 hos fosteret. Kvinnene som ønsker et offentlig tilbud om NIPT for alle, er opptatt av muligheten til informerte valg:
- 63 prosent vil ha mulighet til å avbryte svangerskapet ved alvorlige funn hos fosteret.
- 45 prosent vil være forberedt på å ta vare på et barn med spesielle behov.

NIPT er basert på analyse av cellefritt føtalt DNA fra den gravides blod. Illustrasjon: dbio/Helene Hjorth De som er negative til NIPT i offentlig regi for alle gravide begrunner det blant annet med frykt for et sorteringssamfunn, samt at kvinner uten medisinsk indikasjon bør betale selv.
95 prosent av deltakerne i undersøkelsen hadde hørt om NIPT-test. 18 prosent av dem hadde selv betalt for å få utført testen.
Forskerne som har utført studien konkluderer med at yngre gravide i stor grad ønsker likeverdig tilgang til fosterdiagnostikk. Men selv om alle gravide nå kan kjøpe NIPT via det offentlige, kan prisen føre til at det i praksis ikke er lik tilgang til testen.
De stiller spørsmål ved om lovverket og politikken innen bioteknologi er i tråd med samfunnets forventninger om kvinners rettigheter.
Les hele artikkelen i Tidsskrift for Den norske legeforening: Holdninger til NIPT-test blant gravide under 35 år
Fra privat til offentlig
Lørdag 1. november ble Martina Hansens Hospital i Bærum en del av det offentlige helsevesenet, som del av Vestre Viken helseforetak. Det skriver Budstikka.
Gjennom nesten nitti år har det tidligere privatsykehuset spesialisert seg innen revmatologi og ortopedi. I fjor utførte sykehuset 4400 operasjoner og hadde rundt 40 000 polikliniske konsultasjoner for pasienter fra hele landet.

Martina Hansens Hospital er del av Vestre Viken helseforetak fra 1. november 2025. Administrerende direktør, Kjetil Nerhus, har byttet tittel til klinikkdirektør. Han sier til Budstikka at det er vanskelig å følge med på utviklingen som et lite og privat sykehus. Særlig etter 2018 da endringer i finansieringen reduserte inntektene kraftig, samtidig som også utgiftene har økt på mange områder.
– Det er vanskelig se for seg hvordan vi skulle klart å fortsette som det veldrevne og effektive sykehuset vi er uten å bli tettere del av det offentlige helsevesenet. Det er en rivende utvikling innen helseteknologi. Det er krevende å henge med som et lite, privat sykehus, sier Nerhus.
Avgjørelsen om å bli en del av det offentlige helsevesenet, ble tatt i fjor sommer.
Navnet, Martina Hansens Hospital, forblir det samme, og etter planen skal pasientene ikke merke noe til endringen.
Tidligere var Martina Hansens Hospital eid av en privat stiftelse, som ble opprettet ved hjelp av legatmidler etter Martina Hansen i 1936.
Stiftelsen vil nå bruke midler på å støtte forskning og utvikling. Det forteller styreleder Marianne Hagen til Budstikka.
Vant pris for kvalitet på utdanning
CaseMedLab (CML) – Innovativ læringsarena for bioingeniørfaglig utdanning og praksis – er tildelt Universitetet i Innlandets (INN) utdanningskvalitetspris 2025.
Prisen ble delt ut til førsteamanuensis Elisabeth Ersvær under universitetets årlige festdag torsdag 6. november.

Elisabeth Ersvær er førsteamanuensis og studieprogramansvarlig for bioingeniørutdanningen på Universitetet i Innlandet (INN), og prosjektleder i CaseMedLab. Foto: privat - Takket være hele team CaseMedLab, våre praksispartnere over hele landet og engasjerte studenter, mottok vi denne prisen med stor glede og stolthet, sa Ersvær.
Utdanningskvalitetsprisen har som formål å belønne og stimulere systematisk arbeid med å utvikle kvaliteten på utdanningene ved universitetet.
Med prisen følger heder og ære, og 50 000 kroner til fagmiljøet, som Ersvær opplyser i en e-post vil gå til videre drift av CML.
Universitetet delte samtidig ut tre andre priser: forskningsprisen, samarbeidsprisen og arbeidsmiljøprisen. Les mer om vinnerne her.
Cristin avvikles
Cristin er en database for registrering av forskningsaktivitet for helsesektoren, instituttsektoren og universitets- og høgskolesektoren, som 19. august ble satt i lesemodus. Man kan ikke lenger registrere eller endre på innholdet i Cristin.
Nå har i stedet har 2,2 millioner poster i Cristin blitt flyttet over og gjort søkbare i Nasjonalt vitenarkiv (NVA) – en felles nasjonal løsning for forskningsinformasjon og vitenarkiv.

Nettsidene til Cristin lenker til nyttige forklaringer om prosessen. Skjermdump: Cristin 29.10.25 NVA hadde sin hovedlansering 1. oktober, og er klar til bruk.
Løsningen skal gi en oversikt over norsk forskning, gjøre publikasjoner åpent tilgjengelig og tilrettelegge for gjenbruk av metadata. Kort sagt skal det bli enklere å samle, dele og finne forskningsresultater.
140 forskningsinstitusjoner bruker det nye systemet.
Det er fremdeles mulig å lese data i Cristin, og Sikt vil gi beskjed i god tid før Cristin avvikles og gravlegges for godt.
Det skriver Sikt.
Spørsmål og svar om overgangen kan leses på sidene til Sikt.
Nytt institutt på NTNU fra nyttår
Institutt for bioingeniørfag (IBF) slår seg sammen med Institutt for kjemi (IKJ) på NTNU i Trondheim. Det skriver Universitetsavisa.

Student på bachelor i bioingeniørfag, NTNU. Foto: Per Henning / NTNU Sammenslåingen ble foreslått av de to nåværende instituttlederne Hallstein Hemmer og Lars Gunnar Landrø, kort tid etter at en mer omveltende omorganisering foreslått av dekanen ble stemt ned av fakultetsstyret.

Studenter på bachelor i kjemi, NTNU. Foto: Aleksander Stokke Båtnes / NTNU 
Hallstein Hemmer Foto: Per Harald Olsen / NTNU Det nye instituttet skal hete Institutt for kjemi og bioingeniørfag (IKB), og skal ledes av Hallstein Hemmer.
Flere grunner
Hemmer forteller til Universitetsavisa at det har vært en grundig diskusjon, og en ganske friksjonsfri og smidig prosess – kanskje fordi initiativet denne gangen kom nedenfra.
Grunnene for sammenslåingen er knapp økonomi, og at de nå ønsker å bruke mer ressurser til kjerneaktiviteter som undervisning og forskning – og mindre til administrasjon.
Følger opp ansatte
To punkter ble røde under risikovurderingen som ligger til grunn for vedtaket om sammenslåing: belastningen på administrasjonen, og faren for at det minste instituttet skal føle seg «slukt».
- Det er noe vi skal følge nøye. Jeg skal ha samtaler med alle ansatte før nyttår, og vi planlegger samlinger for å bygge felles kultur, sier Hemmer.
Han vet at mange ikke kjenner hverandre så godt på tvers av de nåværende instituttene i kjemi og bioingeniørfag.
I forbindelse med sammenslåingen skal det også overføres sju ansatte fra materialteknologi til det nye instituttet.
Ny faggruppe
Nåværende leder for Institutt for bioingeniørfag, Lars Gunnar Landrø, forteller på telefon at han vil tre inn i rollen som studieprogramleder for bachelor i bioingeniørfag.

Lars Gunnar Landrø Foto: NTNU - Dette blir bra! Det er ingenting som er som å jobbe med unge, nysgjerrige studenter og fokusere på fag, sier Landrø.
Han ser fram til å sørge for progresjon i studiet, og være med å planlegge emner og innholdet i disse. Institutt for bioingeniørfag leverer i dag 17 av 20 emner til studieprogrammet Bachelor i bioingeniørfag. Fra nyttår vil emnene leveres av det nye instituttet, men av det samme fagmiljøet som tidligere.
Større, men ingen flytting
Landrø tror ikke sammenslåingen av instituttene vil merkes for studentene. Men for de ansatte blir det litt endringer.
Det nye instituttet blir større og mer robust, og nærmeste leder, Hemmer, vil holde til på Gløshaugen men vil bevege seg litt mellom studiestedene. I tillegg vil det nåværende Institutt for bioingeniørfag gå over til å bli en faggruppe for bioingeniørfag og kreftforskning.
- Men ingen skal flytte, forsikrer Landrø, fagmiljøet innen bioingeniørfag forblir på Laboratoriesenteret på Øya som i dag.
Stikk og pengegave fra NITO
Tradisjonen tro stilte NITO med både pengegave og et stunt som involverte bioingeniør Ingvild Eide under årets P3-aksjon.
Radiokanalen har sitt eget opplegg i forbindelse med den årlige TV-aksjonen, og NITO pleier å stille med Ingvild, som utsetter P3-programlederne for stadig nye utfordringer.
Under tidligere aksjoner har de både tatt blodprøve av hverandre, under veiledning av bioingeniøren, blitt utsatt for Ingvilds kjønnssykdom-quiz og en smak- og lukttest av ymse væsker.

Først stikk i fingeren ... Foto: BJARNE KROGSTAD I år var det måling av laktatnivå som stod på programmet. P3-gjengen sykler fra Oslo til Bergen, og i Drammen ble de møtt av Ingvild, som først tok en innledende måling, og så en ny måling etter at syklistene hadde gjennomført en intens spinning-økt.
Så var det tid for overlevering av gaven til aksjonen - en sjekk på 116 504 kroner. Det er én krone for hvert NITO-medlem.

... og så overlevering av NITO-medlemmenes gave til aksjonen. Foto: BJARNE KROGSTAD Statsbudsjettet: Ris - og litt ros - fra NITO BFI
Bioingeniørfaglig institutt (BFI) er kritisk til flere av regjeringens prioriteringer i statsbudsjettet:
- Ingen øremerkede midler til studieplasser på bioingeniørutdanningen ved Universitetet i Innlandet.
- Satsingen på hjemmetester for HPV.
- Kutt i bevilgningen til Forsvarets sanitet.
I et intervju med Dagens Medisin påpeker fagstyreleder Kaja Marienborg og instituttleder Heidi Andersen at regjeringen vil satse på helseteknologi.

Kaja Marienborg og Heidi Andersen. Foto: Bjarne Krogstad - Samtidig satses det ikke på personellet med den nødvendige kompetansen, sier Marienborg, og viser til bioingeniørmangelen og at det ikke utdannes nok bioingeniører.
Når det gjelder hjemmetester for HPV, frykter BFI at man ikke når de kvinnene man håper å nå med dette tiltaket.
Kutt på 40 millioner kroner i Forsvarets sanitet forstår de to lite av.
- Blodberedskapen på sykehusene lider allerede under mangel på personell. Det er ett felles helsevesen, som skal betjene både sivile og militære behov, sier Andersen til Dagens Medisin.
Ros for klokt valg
Regjeringen foreslår et nytt tilskudd på tre millioner kroner som skal gå til kampanjer rettet mot helsepersonell, med formål å redusere overdiagnostikk og overbehandling.
– Vi er strålende fornøyd, sier Marienborg til Dagens Medisin.
Kampanjer av typen "Gjør kloke valg" kan redusere overforbruk av laboratorietjenester.
Vil avvikle refusjon for helprivate
Regjeringa vil ikke lenger dekke kostnadene til laboratorieprøver bestilt av helprivate aktører som ikke har avtale med det offentlige. Det skriver Dagens medisin.
Inntil 258 millioner kroner anslår Regjeringa å kunne spare i 2026 på å la de helprivate aktørene ta regninga selv.

llustrasjonsfoto: Annette Larsen Forslaget ble lagt fram onsdag 15. oktober da finansminister Jens Stoltenberg presenterte regjeringas nye statsbudsjett.
Hvordan tiltaket skal gjennomføres, skal først ut på en offentlig høring. Dersom forslaget blir vedtatt, vil endringen tre i kraft fra 1. mai 2026.
Ny smittevernlov
Onsdag 8.oktober klokka 10:30 la helse- og omsorgsminister Jan Christian Vestre (Ap) fram forslag om en ny smittevernlov. Det skriver regjeringa på sine nettsider.

Smittevernloven og loven om helseberedskap oppdateres. Illustrasjonsfoto: iStock Både ny smittevernlov og ny helseberedskapslov sendes ut på høring etter å ha blir presentert 8. oktober. Opptak av pressekonferansen kan sees her.
Endringene kommer etter at koronakommisjonen anbefalte regjeringen å gå gjennom eksisterende lover etter erfaringer under koronapandemien.
Under pandemien var det smittevernloven som ga myndighetene hjemmel til å stenge ned ulike deler av samfunnet.
Ny koordinator for labtjenester
Anne-Berit Johannessen er ansatt som ny koordinator for laboratorietjenester i Helse Nord.
Johannessen kom fra stillingen som nestleder for Team Servicedesk hos Serit Tromsø, og har bakgrunn både som bioingeniør og IT-konsulent.
I et innlegg på LinkedIn skriver hun:
«Etter et par år i IT-verden er jeg tilbake til mitt hjertebarn – laboratoriedrift på sykehus.»

Anne-Berit Johannessen gleder seg over å jobbe med laboratoriedrift igjen. Foto: David Jensen I hennes nye stilling skal hun blant annet bidra til bedre samarbeid på tvers av regionen, finne smarte løsninger for oppgavedeling og vaktordninger, og bruke teknologi til å avlaste bioingeniører og andre yrkesgrupper på laboratoriet.
Stillingen er opprettet etter et mandat fra styret i Helse Nord, som ønsker å møte den økende mangelen på bioingeniører.
Johannessen skriver at hun ser fram til å styrke og utvikle bioingeniørfaget, og bidra til bærekraftige laboratorietjenester i årene som kommer.
IFBLS-pris til Marie Roald
Marie Roald mottok nylig IFBLS Fellowship Award på et IFBLS-møte i Stockholm. Hensikten med prisen er å synliggjøre gode bioingeniørledere over hele verden.
- Jeg er både beæret og ydmyk for å få denne utmerkelsen, og har et brennende hjerte for internasjonalt arbeid, skriver Roald i en e-post.

Marie Roald Foto: Anders Olsson Roald har vært aktiv i IFBLS i mange år - blant annet som organisasjonens president. I dag bidrar hun i IFBLS sitt arbeid med å lage en internasjonal oversikt over bioingeniørutdanning i ulike land, i tillegg til å være engasjert i arbeidet med det vitenskapelige tidsskriftet som drives av IFBLS, International Journal of Biomedical Laboratory Science (IJBLS).
- Det å arbeide internasjonalt er lærerikt, utviklende og til tider krevende, men gir mye inspirasjon og energi, sier Roald.
Hun synes det er nyttig å se bioingeniørenes rolle i helsetjenesten i et internasjonalt perspektiv, og blir fortsatt inspirert av å se hvor like bioingeniører er selv om rammebetingelsene og forutsetningene varierer veldig rundt om i verden.
Kriteriene for å kunne motta Fellowship-prisen kan leses her.
International Federation of Biomedical Laboratory Science (IFBLS) er den internasjonale organisasjonen for bioingeniører, og representerer over 240 000 bioingeniører i 38 land.
Roald var nominert av Sverige. Hun var ikke selv til stede under prisutdelingen, og NITO BFIs Fagstyreleder Kaja Marienborg mottok prisen på hennes vegne.
Bioingeniører nominert til årets NITO-pris
For sin bacheloroppgave om aluminium i vaksiner og hvordan aluminium påvirker immunresponsen vaksiner gir, er Hedda Sirevåg Ødegård og Jacqueline Acurio Dalby nominerte til årets NITO-pris.
- Vi er stolte av og takknemlige for at arbeidet vårt blir anerkjent på denne måten! skriver Ødegård og Dalby i en e-post.

Hedda Sirevåg Ødegård (til venstre) og Jacqueline Acurio Dalby på Malmø universitet der de utførte forskningsarbeidet til bachelorprosjektet. Foto: privat De forteller at det har vært spennende og lærerikt å fordype seg i et så interessant og samfunnsrelevant tema som vaksiner – og synes det er stort å bli nominert.
At bachelorprosjekter fra bioingeniørutdanningene også blir trukket fram og nominert, er viktig for dem.
Dalby og Ødegård er tidligere bioingeniørstudenter ved Høgskolen i Østfold (HiØ) og leverte bacheloroppgaven sin rett før sommeren i år.
Da deltok de samtidig på Høgskolen i Østfold (HiØ) sin BIO EXPO, en utstilling der studenter fra HiØ presenterer bacheloroppgavene sine som postere – og vant prisen for beste poster. Tittelen på prosjektet deres er «Påvirker fagocytose av aluminiumbasert adjuvant makrofagers energiforbruk og produksjon av reaktive oksygensubstanser?».
Ny pris og flere nominerte
NITO-prisen ble delt ut for første gang høsten 2024. Da vant fem byggingeniører på OsloMet prisen for bacheloroppgaven sin om bærekraftige veiprosjekter.
I år er det satt særlig søkelys på kandidater som har levert oppgaver om innovasjon, kompleksitet, de store samfunnsutfordringene og bærekraft.
Relevante høyskoler og universiteter i Norge har muligheten til å nominere inntil to kandidater for årets beste bachelor- eller masteroppgave innen ingeniør- og teknologifag.
Vinneren blir presentert på NITOs landsmøte 26.–27. november og vil motta en pris samt en pengesum på 50 000 kroner.
St. Olav blir Kloke valg-sykehus
Som det første universitetssykehuset i Norge blir St. Olavs hospital i Trondheim sertifisert som Kloke valg-sykehus.

Tom Christian Martinsen Foto: St. Olavs hospital Ett av St. Olavs tre satsningsområder er å redusere bildediagnostikk og laboratorieprøver med lav nytte for pasientene. Det håper administrerende direktør Tom Christian Martinsen skal frigi mer kapasitet til de av pasientene som trenger hjelpen mest.
- Vi mener det er klokt å gjøre mer av det som virker, og mindre av det som ikke har en verdi for pasientene, sier Martinsen i en sak på St. Olav sine nettsider.
Han forteller videre at Kloke valg skaper et stort faglig engasjement, og at fagmiljøene i den enkelte klinikk vil være med og definere hvilke kloke valg som er relevante å innføre.
Sykehuset i Vestfold ble Norges første Kloke valg-sykehus i mars i år, og Sykehuset Innlandet fulgte etter i august.
Gjør kloke valg-kampanjen er et initiativ fra Den norske legeforening, som har som mål å redusere overdiagnostikk og overbehandling.
Som en del av dette, har kampanjen utarbeidet kriterier for at et sykehus skal kunne kalle seg Kloke valg-sykehus. Sykehuset må ta i bruk minst fem «Kloke valg»-anbefalinger fra fagmedisinske foreninger og starte minst to forbedringsprosjekter. Alle ansatte skal lære om «Gjør kloke valg».
Rask spredning av Candida auris
Gjærsoppen har spredt seg raskt på flere europeiske sykehus i siste årene. Det melder det europeiske smittevernbyrået (ECDC) i en fersk rapport, The C. auris survey 2024.
Rapporten viser at over 4000 tilfeller av kolonisering eller infeksjon med gjærsoppen ble meldt inn av EU/EØS-land i perioden 2013-2023, med Spania, Hellas, Italia, Romania og Tyskland på topp.
Det er særlig etter 2020 blitt meldt om stor økning, hvor 1346 tilfeller ble meldt inn av totalt 18 land.
Gjærsoppen Candida auris er på frammarsj i Europeiske sykehus. Illustrasjonsfoto: iStock/TopMicrobialStock ECDC tror dette bare er toppen av isfjellet, da flere land mangler systematisk overvåkning av gjærsoppen.
C. auris er motstandsdyktig mot vanlig antibiotika, og kan gi alvorlig infeksjon hos kritisk syke pasienter - i verste fall med dødelig utfall.
I Norge er gjærsoppen sjelden, men Folkehelseinstituttet følger likevel nøye med på utviklingen i Europa. I fjor ble det meldt om seks tilfeller av gjærsoppinfeksjon her til lands, og bare to hittil i år.
– Pasienter med nedsatt immunforsvar er særlig utsatt, og det har vært en økende bekymring knyttet til medikamentresistens for nettopp denne arten, sier Espen Rostrup Nakstad, leder for Nasjonal behandlingstjeneste for CBRNE-medisin ved Oslo universitetssykehus, til Dagens medisin.
Bioingeniør inn i Direktoratet for strålevern og atomsikkerhet
Etter 16 år hos Folkehelseinstituttet har Hildegunn Dahl startet i ny jobb hos Direktoratet for strålevern og atomsikkerhet (DSA).
Som fagdirektør ved seksjon kunnskapsutvikling skal hun koordinere arbeidet med videreutviklingen av et teknisk vitenskapelig nettverk (TSO-nettverk).

Hildegunn Dahl har byttet jobb. Foto: privat DSAs TSO-nettverk utvikles i tråd med det internasjonale atomenergibyråets (IAEA) prinsipper for teknisk og vitenskapelig støtte til stråleverns- og atomsikkerhetsmyndigheter, nemlig «Technical and Scientific Support Organizations» eller TSO.
Nettverket skal bidra til å styrke kunnskapsgrunnlaget for beslutninger innen atomsikkerhet og strålevern, blant annet gjennom samarbeid med relevante nasjonale og internasjonale forskningsmiljøer.
- Det er viktig å sørge for en solid kunnskapsbase for å møte dagens og fremtidige utfordringer innen DSAs myndighetsområde, forteller Dahl.
Fag- og forvaltningsmyndigheten DSA arbeider for å redusere negative følger av stråling i samfunnet. Det innebærer riktig og forsvarlig håndtering av strålekilder, medisinsk strålebruk og radioaktivt avfall, samt redusere folks eksponering for UV-stråling fra sol og solarium og radon innendørs. DSA er også ansvarlig for den nasjonale atomberedskapen, og arbeider for økt atomsikkerhet både nasjonalt og internasjonalt.
Europeisk konferanse om utdanning i Bergen
Høgskulen på Vestlandet (HVL) arrangerer en europeisk utdanningskonferanse for bioingeniører i november: The 2nd European Conference on Biomedical Laboratory Sciences Education (ECBLSE) - Western Norway University of Applied Sciences

Gry Sjøholt (til venstre) er leder for konferansens vitenskapelige komité og Line Wergeland leder den lokale organisasjonskomiteen. Begge to er førsteamanuenser ved bioingeniørutdanningen på HVL. Foto: privat Tema i år er harmonisering av bioingeniørutdanningene i Europa, og tilpasning til fagområdets raske endringer.
Hvordan samarbeid innen utveksling kan styrkes, utvikling av utdanningen og forskning og innovasjon, vektlegges også.
Nylig gikk fristen for early-bird-påmelding ut, og da var det allerede over 30 deltakere påmeldte fra seks forskjellige europeiske land.
- Vi håper på 60-80 påmeldte, forteller Line Wergeland som leder konferansens lokale komité.
Hovedinnlegget på programmet skal holdes av presidenten i EPBS (European Association of Biomedical Scientists), professor Fernando Mendes.
Konferansens postersesjon handler om utvikling av bioingeniørutdanninga for framtida, og det er fremdeles mulig å sende inn abstrakt.
Den første konferansen ble arrangert for to år siden i Coimbra i Portugal.
Regjeringen vil utvikle KI-basert helsepraterobot
Den skal kunne svare på helsespørsmål befolkningen allerede spør ChatGPT eller Google om. Det skriver TV2.
Helseminister Jan Christian Vestre peker på at eksisterende KI-tjenester allerede får mange spørsmål – om alt fra insektbitt til angst, søvnvansker og ensomhet.

Illustrasjon: iStockphoto - Vi skylder befolkningen å lage gode og tilgjengelige løsninger som er i takt med tiden. Over tid har vi også bygget opp mye informasjon som befolkningen burde ha trygg og enkel tilgang til, sier Vestre til TV2.
Tanken er at bilder av for eksempel insektbitt og utslett kan lastes opp, og sammen med en beskrivelse av symptomene skal den digitale helserådgiveren kunne gi en gode råd om hva en bør gjøre, og når en bør dra til legevakt eller fastlegen.

Helseminister Jan Christian Vestre Foto: David Berg Tvetene (NFD) Det tror Vestre vil bidra til å avlaste helsetjenesten.
Han ønsker å tilby en heldigital helserådgiver som er tilgjengelig 24 timer i døgnet, sju dager i uka – og best av alt: Den har ingen venteliste.
Helsedirektoratet har fått oppgaven med å undersøke hvordan helseprateroboten kan lages på en forsvarlig måte.
Målet er å bruke KI på en trygg og etisk måte, der svarene tjenesten gir skal være i tråd med medisinsk og helsefaglig praksis.